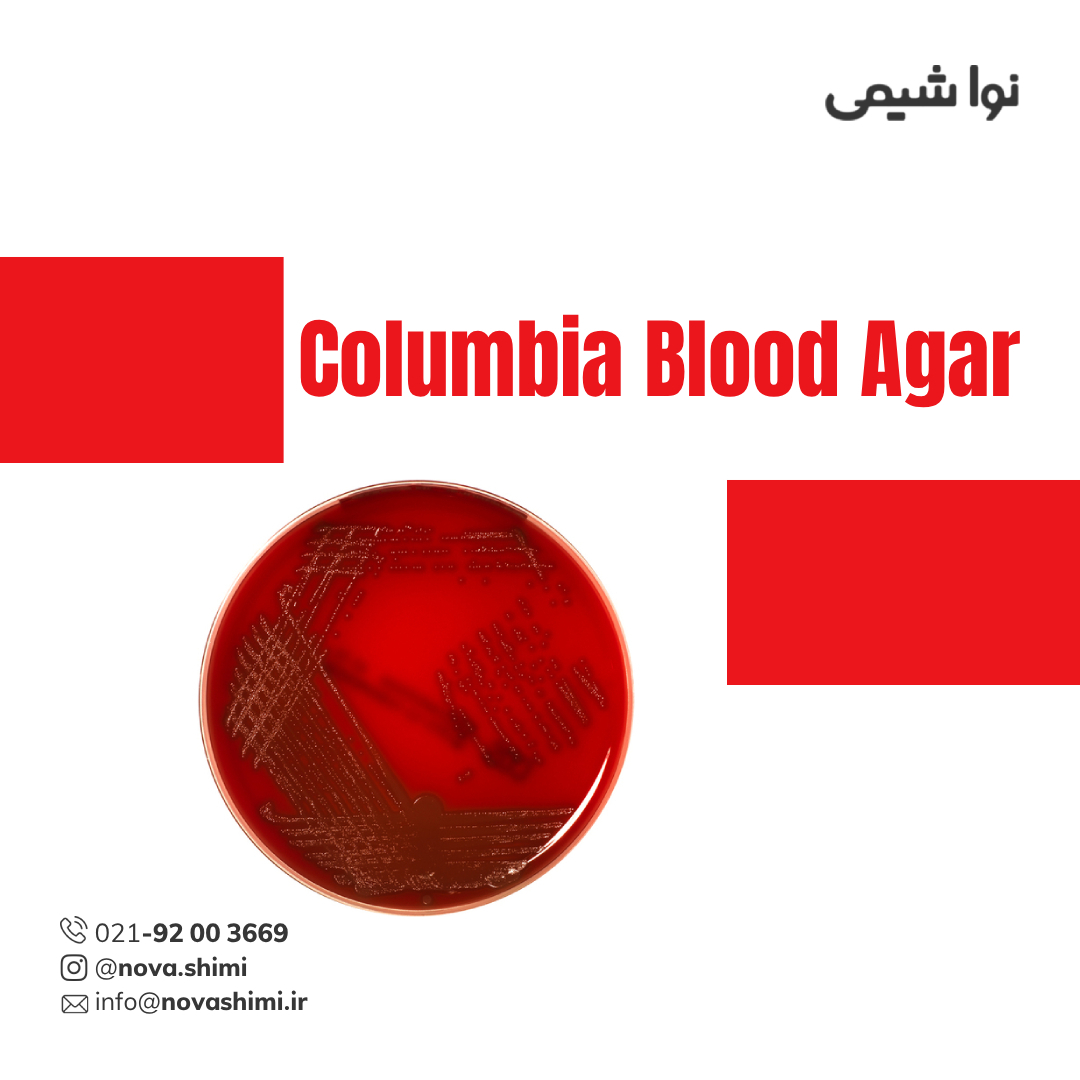
محیط کشت کلمبیا بلاد آگار مرک (Columbia Blood Agar)
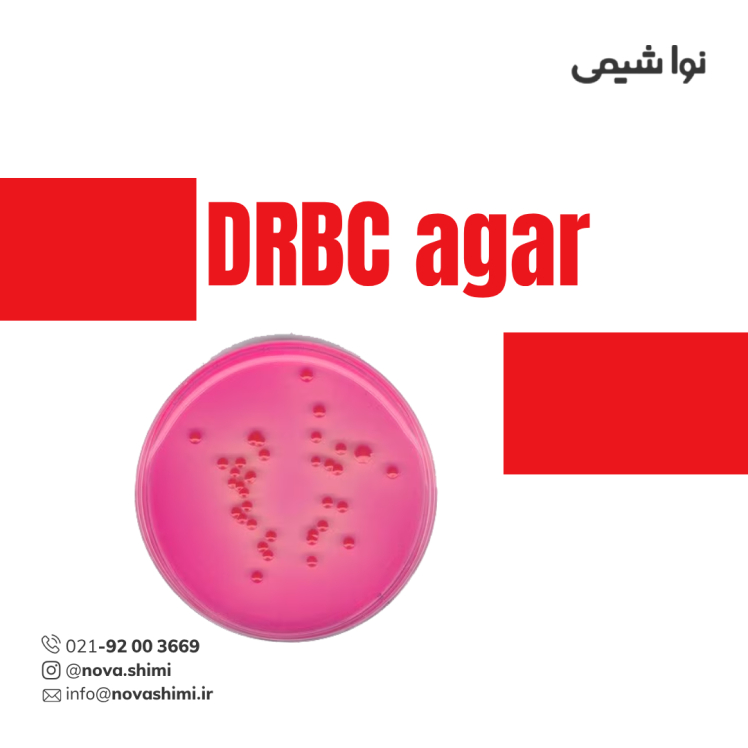
محیط کشت DRBC آگار مرک (GranuCult® prime DRBC agar)

محیط کشت کلمبیا بلاد آگار مرک (Columbia Blood Agar)
مشخصات فنی محیط کشت کلمبیا بلاد آگار:
1. برند: Merck Millipore
2. کاربرد: کشت باکتریهای پرمصرف و غیرپرمصرف، بررسی همولیز، استفاده در نمونههای کلینیکی و دارویی
3. فرم فیزیکی: صفحات آماده استفاده (Ready-to-use settle plates)
4. تعداد در بسته: جعبه ۲۰ یا ۱۲۰ عدد صفحه ۹۰ میلیمتری
محیط کشت کلمبیا بلاد آگار چیست؟
محیط کشت Columbia Blood Agar مرک برای جداسازی و کشت باکتریهای پرمصرف و غیرپرمصرف، تشخیص همولیز و تحقیقات میکروبیولوژی نمونههای کلینیکی و دارویی مناسب است. شرکت نُـواشیمی، به عنوان یکی از تامین کنندگان مواد آزمایشگاهی و محیط کشت برند مرک و سیگما آلدریچ، آماده ارائه خدمات فروش محیط کشت کلمبیا بلاد آگار کد 146559 به شما عزیزان خواهد بود. برای دریافت اطلاعات فنی و استعلام قیمت محیط کشت کلمبیا بلاد آگار مرک، از طریق شماره 02192003669 با کارشناسان فروش نُـوا شیمی تماس حاصل فرمایید.
برای آشنایی بیشتر با ویژگیها و مشخصات محصول، میتوانید با کلیک روی هر عنوان، به توضیحات تکمیلی در زیرعنوانهای مربوطه دسترسی پیدا کنید.
مشخصات محصول (Product Specifications)
مشخصات فنی محیط کشت کلمبیا بلاد آگار (OSA) (Product Specifications)
در جدول زیر میتوانید مشخصات فنی کامل محیط کشت Columbia Blood Agar مرک (plate diam. 90 mm, ready-to-use, settle plates, sterile) را مشاهده کنید.
ویژگی | توضیح |
|---|---|
کد محصول (Cat. No.) | 1.46559 |
برند / تولیدکننده | Merck (Millipore) |
نام تجاری | Columbia Blood Agar |
فرم فیزیکی | صفحات آماده استفاده (Ready-to-use settle plates) |
قطر صفحه (Plate diameter) | 90 mm |
حالت استریل | استریل |
سطح کیفیت (Quality Level) | 300 |
بستهبندی | جعبه شامل ۲۰ یا ۱۲۰ صفحه |
pH | 7.3 (در آب) |
کاربردها | میکروبیولوژی، نمونههای دارویی |
مناسب برای | باکتریهای پرمصرف (Fastidious) و غیرپرمصرف |
دمای نگهداری | 2–8°C |
برای مشاهده اطلاعات کامل محصول در سایت مرک و جزئیات کاربردی آن، بر روی Columbia Blood Agar کلیک کنید. شرکت نُـوا شیمی، تأمینکننده انواع محیط کشت برندهای معتبر مانند مرک و سیگما آلدریچ است و امکان خرید آسان و مطمئن این محصولات آزمایشگاهی را برای شما فراهم میکند.
آنالیز و کیفیت (Analysis Note)
ویژگیهای آنالیزی و کیفیت (Analysis Note)
Appearance (clearness): شفاف تا اندکی اوپالسنت
Appearance (colour): قرمز خونین (به دلیل خون گوسفند)
pH-value (25°C, after preparation): 7.3
Growth promotion test: مطابق با استانداردهای میکروبیولوژی برای باکتریهای پرمصرف و غیرپرمصرف
Recovery rate: ≥ 70% برای گونههای استاندارد باکتریهای Fastidious
Hemolysis detection: امکان مشاهده واضح واکنشهای همولیتیک
جدول راهنمای ویژگیهای آنالیزی محیط کشت کلمبیا بلاد آگار
ویژگی | توضیح کامل |
|---|---|
شکل ظاهری (Appearance - clearness) | پس از آمادهسازی، صفحه کشت شفاف تا اندکی اوپالسنت است. این ویژگی کیفیت بالای محیط و نبود ناخالصی را نشان میدهد. |
رنگ (Appearance - colour) | رنگ قرمز خونین محیط کشت ناشی از افزودن خون گوسفند است و امکان تشخیص واکنشهای همولیز را فراهم میکند. |
pH-value (25°C) | مقدار pH حدود 7.3 است. pH مناسب باعث رشد بهینه باکتریهای Fastidious و غیرپرمصرف میشود. |
تست رشد (Growth promotion test) | محیط مطابق استانداردهای میکروبیولوژی آزمایش شده تا توانایی پرورش باکتریهای هدف تضمین شود. |
کلونیهای مرجع (Colony count on reference medium) | تعداد کلونیها پس از تلقیح باکتریهای استاندارد Fastidious ثبت میشود تا عملکرد محیط بررسی شود. |
درصد بازیابی (Recovery on test medium) | بازیابی ≥70% کلونیها نشاندهنده توانایی محیط در حمایت از رشد باکتریها است. |
تشخیص همولیز (Hemolysis detection) | صفحات خوندار امکان مشاهده واضح واکنشهای α، β و γ همولیز را فراهم میکند. |
دمای انکوباسیون (Incubation) | محیط برای رشد باکتریهای پرمصرف و غیرپرمصرف در دمای 35–37°C به مدت 24–48 ساعت انکوبه میشود. |
خرید محیط کشت کلمبیا بلاد آگار مرک (Orange Serum agar)
خرید محیط کشت کلمبیا بلاد آگار (Columbia Blood Agar) مرک کد 146559
محصول محیط کشت Columbia Blood Agar مرک یک محیط کشت آماده استفاده و استریل است که بهطور ویژه برای رشد باکتریهای پرمصرف (Fastidious) و غیرپرمصرف طراحی شده است. این محیط با افزودن خون گوسفند، امکان تشخیص واکنشهای همولیتیک (α، β و γ) را فراهم میکند و شرایط بهینه برای رشد سریع و با کیفیت کلونیها را ایجاد مینماید.
محیط کشت Columbia Blood Agar مرک در تحقیقات میکروبیولوژی، کنترل کیفیت نمونههای دارویی و کلینیکی و بررسی دقیق خصوصیات کلنیها کاربرد دارد و با تکنولوژی استاندارد GranuCult® یا صفحات آماده، راحتی استفاده و تکرارپذیری بالا را تضمین میکند.
کمپانی مِرک (MERCK)
شرکت مرک (Merck KGaA) یکی از قدیمیترین و معتبرترین کمپانیهای علمی و فناوری در جهان است که در سال 1668 در آلمان تأسیس شد و امروزه بهعنوان پیشگام جهانی در حوزههای مواد شیمیایی آزمایشگاهی، بیوتکنولوژی و داروسازی شناخته میشود. بخش مواد آزمایشگاهی مرک، طیف گستردهای از مواد شیمیایی با گریدهای مختلف از جمله آنالیتیکال، ACS، HPLC، و Suprapur® را ارائه میدهد که برای تحقیقات علمی، کنترل کیفیت صنعتی، و مصارف آموزشی کاربرد دارند
شرکت نُـوا شیمی، تامین کننده مواد آزمایشگاهی محیط کشت
شرکت نُـوا شیمی، با سابقهای درخشان در تامین مواد آزمایشگاهی، استاندارد ها و تجهیزات آزمایشگاه، با دسترسی گسترده به محصولات برندهای معتبر داخلی و بینالمللی، تامین نیازهای صنایع، آزمایشگاههای تحقیقاتی و داروسازی را با رویکردی مدرن و دقیق دنبال میکند. در صورت نیاز به استعلام قیمت محیط کشت کلمبیا بلاد آگار مرک کد 146559 یا سایر مواد آزمایشگاهی، استاندارد و رفرنسهای آزمایشگاهی کارشناسان ما از طریق خط ویژه 02192003669 آماده پاسخگویی و ارائه مشاوره تخصصی به شما خواهند بود.
کاربرد های محیط کشت OSA
مهمترین کاربردهای محیط کشت کلمبیا بلاد آگار:
در ادامه، کاربردهای محیط کشت کلمبیا بلاد آگار مرک را مطالعه خواهیم نمود:
۱. جداسازی و شناسایی باکتریهای پرمصرف (Fastidious bacteria)
محیط کشت Columbia Blood Agar مرک بهطور خاص برای رشد باکتریهایی طراحی شده است که نیاز به فاکتورهای تغذیهای خاص دارند، مانند Haemophilus spp.، Neisseria spp. و Streptococcus spp.. وجود خون گوسفند در محیط، فاکتور X (heme) و سایر مواد مغذی را برای رشد مطلوب این باکتریها فراهم میکند.
۲. بررسی واکنشهای همولیتیک (Hemolysis test)
یکی از مهمترین کاربردهای این محیط، تشخیص نوع همولیز (α، β و γ) در کلونیهای باکتریایی است.
این تست برای شناسایی گونههای استرپتوکوک و برخی دیگر از باکتریها بسیار حیاتی است و با مشاهده ناحیه شفاف یا تغییر رنگ اطراف کلونیها انجام میشود.
۳. رشد باکتریهای بیهوازی و هوازی
Columbia Blood Agar محیطی چندمنظوره است که میتواند برای رشد گونههای هوازی و بیهوازی مورد استفاده قرار گیرد. این ویژگی باعث میشود در آزمایشگاههای بالینی و صنعتی، گزینهای مناسب برای بررسی انواع نمونهها باشد.
۴. کاربرد در صنایع داروسازی (Pharmaceutical microbiology)
در کنترل کیفی فرآوردههای دارویی و مواد اولیه دارویی، از Columbia Blood Agar مرک برای بررسی وجود آلودگیهای میکروبی، رشد باکتریهای خاص و آزمونهای میکروبی مطابق فارماکوپهها استفاده میشود.
۵. کشت مخمرها و قارچها (Yeasts and molds)
هرچند کاربرد اصلی آن برای باکتریهاست، اما ترکیب غنی این محیط میتواند رشد برخی گونههای قارچی و مخمری مانند Candida albicans را نیز پشتیبانی کند.
برای دریافت استعلام قیمت محیط کشت کلمبیا بلاد آگار مرک کد 146559، لطفا با شماره 02192003669 تماس حاصل فرمایید. کارشناسان ما آماده پاسخگویی به سوالات شما هستند.
نکات ایمنی
نکات ایمنی و نگهداری (Safety & Storage)
در ادامه نکات ایمنی استفاده از محیط کشت کلمبیا بلاد آگار (Columbia Blood Agar) برند مرک را مطالعه خواهیم نمود:
مورد | توضیح |
|---|---|
کلاس ذخیرهسازی (Storage Class Code) | 11 – Combustible Solids (جامدات قابل اشتعال) |
WGK (درجه خطر زیستمحیطی آب) | WGK 2 – ماده با خطر متوسط برای آب |
شرایط نگهداری (Storage Conditions) | در دمای ۲ تا ۸ درجه سانتیگراد و به دور از نور مستقیم نگهداری شود. از یخزدگی محیط جلوگیری گردد. |
وضعیت استریل بودن (Sterility) | استریل و آماده استفاده – درب بسته و در محیط تمیز نگهداری شود تا آلودگی ثانویه ایجاد نشود. |
احتیاط در کار با ماده (Precautions) | هنگام باز کردن درب پلیت از تماس مستقیم دست یا ابزار غیراستریل با سطح محیط خودداری شود. در شرایط بهداشتی و زیر هود لامینار کار شود. |
تهویه محیط کار (Ventilation) | در هنگام انجام کشتهای میکروبی، از هود بیولوژیکی کلاس II یا محیط دارای تهویه مناسب استفاده گردد. |
دفع پسماند (Disposal) | پس از استفاده، پلیتها باید در اتوکلاو در دمای 121°C به مدت 15 دقیقه استریل و سپس مطابق با دستورالعمل ضایعات زیستی دفع شوند. |
خطرات بالقوه (Hazards) | خطر خاصی ندارد اما در صورت رشد باکتریهای پاتوژن باید به عنوان پسماند زیستی با خطر متوسط تا بالا مدیریت شود. |
اگر به دنبال محیط کشت کلمبیا بلاد آگار (Columbia Blood Agar) هستید، نُـوا شیمی همراهی مطمئن در مسیر تامین نیاز های شما خواهد بود. برای سفارش، دریافت مشاوره فنی و آگاهی از شرایط همکاری؛ از طریق شماره 02192003669 با تیم فروش در ارتباط باشید.
سوالات متداول (FAQ)
سوالات متداول درباره محیط کشت کلمبیا بلاد آگار مرک (FAQ)
1. محیط کشت Columbia Blood Agar مرک چیست و چه کاربردی دارد؟
این محیط کشت آماده و استریل برای رشد و شناسایی باکتریهای پرمصرف (Fastidious) و غیرپرمصرف استفاده میشود. به دلیل وجود خون گوسفند، برای بررسی واکنشهای همولیتیک (α، β، γ) در نمونههای میکروبی نیز بسیار مناسب است.
2. تفاوت محیط Columbia Blood Agar با Blood Agar معمولی چیست؟
در محیط Columbia Blood Agar از پایهی غنیتر Columbia Agar Base استفاده شده که حاوی مواد مغذی بیشتر از جمله پپتونها و نشاسته است. این تفاوت موجب رشد سریعتر، رنگدانه بهتر و واکنشهای همولیتیک دقیقتر میشود.
3. چه نوع باکتریهایی در Columbia Blood Agar رشد میکنند؟
این محیط برای رشد گونههای پرمصرفی مانند Streptococcus spp.، Staphylococcus aureus، Haemophilus influenzae، Neisseria spp. و بسیاری از باکتریهای بیهوازی یا کمهوازی مناسب است.
4. آیا این محیط برای آزمایشهای دارویی و کنترل کیفی هم کاربرد دارد؟
بله. محیط کشت Columbia Blood Agar مرک در کنترل کیفی داروها، محصولات آرایشی و بهداشتی، و نمونههای کلینیکی جهت تشخیص آلودگیهای باکتریایی استفاده میشود.
5. شرایط نگهداری مناسب برای Columbia Blood Agar چیست؟
باید در دمای ۲ تا ۸ درجه سانتیگراد، بهدور از نور مستقیم و در وضعیت افقی نگهداری شود تا سطح آگار دچار ترکخوردگی یا خشک شدن نشود.
6. زمان انقضا و پایداری محیط چقدر است؟
در شرایط مناسب نگهداری، تا ۳ ماه پس از تولید قابل استفاده است. پس از باز کردن بسته، بهتر است ظرف چند روز مصرف شود تا از آلودگی و خشک شدن جلوگیری گردد.
7. آیا Columbia Blood Agar برای رشد قارچها هم مناسب است؟
خیر. این محیط برای رشد باکتریهای پرمصرف و غیرپرمصرف طراحی شده است. برای قارچها و مخمرها بهتر است از محیطهایی مانند Sabouraud Dextrose Agar استفاده شود.

هنوز نظری ثبت نشده
اولین نفری باشید که نظر میدهید
ثبت نظر